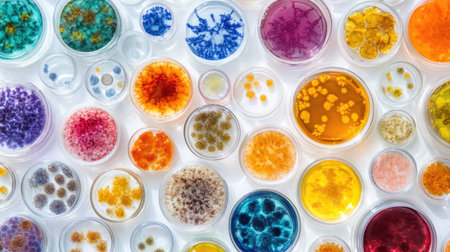
A cluster of various biological samples, including cells and microorganisms in petri dishes.の素材

素材 - A cluster of various biological samples, including cells and microorganisms in petri dishes.
作品情報
A cluster of various biological samples, including cells and microorganisms in petri dishes.
- ID:257570779
- 作品種別:
- 作者名:Kitsanaphong burarat
キーワード
- addiction
- analyzing
- antibiotic
- biochemistry
- biology
- biotechnology
- blood
- bucharest
- chemical
- chemistry
- close-up
- color image
- concepts
- dieting
- epidemic
- equipment
- hand
- healthcare and medicine
- high angle view
- hiv
- horizontal
- human hand
- illness
- laboratory
- liquid
- medicine
- microbiology
- multi colored
- no people
- one person
- people
- pill
- progress
- research
- romania
- science
- spain
- studio shot
- technician
- technology
- test tube
- tube
- tubing
- uk
- vial
- vitamin
類似作品
microbial cultu...
Colorful variet...
cluster of petr...
microscope slid...
microbial cultu...
collection of d...
microbial cultu...
microbial cultu...
dish chemistry ...
petri dish with...
microbial cultu...
microbial cultu...
Close-up of sci...
petri dish with...
Colorful bacter...
petri dishes wi...
A cluster of va...
Microbial Colon...
female hand in ...
Colorful variet...
A diverse array...
lab samples of ...
microbial cultu...
Scientist is sh...
Mold and other ...
microbial cultu...
3d illustration...
petri dish with...
A captivating d...
Test tubes with...
Top view of a p...
close-up of vib...
person, conduct...
Hands, plant sc...
microscope slid...
Different types...
close-up of pet...
Colorful variet...
Various colorfu...
microbial cultu...
A diverse array...
Various colorfu...
Petri dishes co...
microbial cultu...
Test tubes with...
Colorful ink sp...
Sample under th...
culture petri d...
Background with...